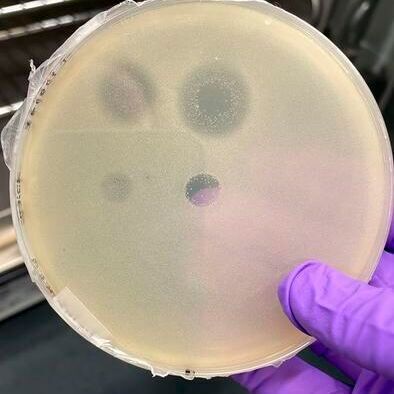
The salt-loving Halalkalibacterium halodurans, growing on a petri dish in the Warnecke lab, is killed by proteins secreted by the archaeon Halogranum salarium.(Source:  Aida Sanchez-Ricol)

Date: 08.12.2025
Naturally, we always handle your personal data responsibly. Any personal data we receive from you is processed in accordance with applicable data protection legislation. For detailed information please see our privacy policy.
Consent to the use of data for promotional purposes
I hereby consent to Vogel Communications Group GmbH & Co. KG, Max-Planck-Str. 7-9, 97082 Würzburg including any affiliated companies according to §§ 15 et seq. AktG (hereafter: Vogel Communications Group) using my e-mail address to send editorial newsletters. A list of all affiliated companies can be found here
Newsletter content may include all products and services of any companies mentioned above, including for example specialist journals and books, events and fairs as well as event-related products and services, print and digital media offers and services such as additional (editorial) newsletters, raffles, lead campaigns, market research both online and offline, specialist webportals and e-learning offers. In case my personal telephone number has also been collected, it may be used for offers of aforementioned products, for services of the companies mentioned above, and market research purposes.
Additionally, my consent also includes the processing of my email address and telephone number for data matching for marketing purposes with select advertising partners such as LinkedIn, Google, and Meta. For this, Vogel Communications Group may transmit said data in hashed form to the advertising partners who then use said data to determine whether I am also a member of the mentioned advertising partner portals. Vogel Communications Group uses this feature for the purposes of re-targeting (up-selling, cross-selling, and customer loyalty), generating so-called look-alike audiences for acquisition of new customers, and as basis for exclusion for on-going advertising campaigns. Further information can be found in section “data matching for marketing purposes”.
In case I access protected data on Internet portals of Vogel Communications Group including any affiliated companies according to §§ 15 et seq. AktG, I need to provide further data in order to register for the access to such content. In return for this free access to editorial content, my data may be used in accordance with this consent for the purposes stated here. This does not apply to data matching for marketing purposes.
Right of revocation
I understand that I can revoke my consent at will. My revocation does not change the lawfulness of data processing that was conducted based on my consent leading up to my revocation. One option to declare my revocation is to use the contact form found at https://contact.vogel.de. In case I no longer wish to receive certain newsletters, I have subscribed to, I can also click on the unsubscribe link included at the end of a newsletter. Further information regarding my right of revocation and the implementation of it as well as the consequences of my revocation can be found in the data protection declaration, section editorial newsletter.





:quality(80)/p7i.vogel.de/wcms/ac/24/ac2495bc671ef2a8bf95bdb0de7f172a/0131908887v1.jpeg)
:quality(80)/p7i.vogel.de/wcms/dd/be/ddbe621ac35ec49d9aee43615173f703/0131898392v2.jpeg)
:quality(80)/p7i.vogel.de/wcms/e2/ae/e2aea4192de2e22dd33d19afee25f312/0131779278v1.jpeg)
:quality(80)/p7i.vogel.de/wcms/49/03/49033fd7e1cb79cd90776e8d0583b441/0131773380v1.jpeg)
:quality(80)/p7i.vogel.de/wcms/f5/8d/f58d7181bd0660dea9e33b89f15947eb/0131589395v2.jpeg)
:quality(80)/p7i.vogel.de/wcms/63/44/63443a618001fbdc12e18de386a7b548/0131588936v2.jpeg)
:quality(80)/p7i.vogel.de/wcms/47/13/4713969ee1fed4c9d6cd932df7c82482/0131588920v2.jpeg)
:quality(80)/p7i.vogel.de/wcms/45/d9/45d9cf5be3c10b389fd712f319fbfce1/0131588911v2.jpeg)
:quality(80)/p7i.vogel.de/wcms/b6/6a/b66a4a25066ff8e426cd9f574b72c7b9/0131905275v1.jpeg)
:quality(80)/p7i.vogel.de/wcms/9f/d8/9fd8ffb67c1132b4f48dc60e4e194226/0131784166v2.jpeg)
:quality(80)/p7i.vogel.de/wcms/3e/47/3e472068bf13aadf4786e947ae148759/0131779258v2.jpeg)
:quality(80)/p7i.vogel.de/wcms/bc/bc/bcbcf8be4b6c996f6ff231cb65937953/0131673749v1.jpeg)
:quality(80)/p7i.vogel.de/wcms/ac/33/ac339ce19b25f78e11a8dc8ef137869b/0131904977v2.jpeg)
:quality(80)/p7i.vogel.de/wcms/b2/f9/b2f99d68013e2a6ab65e6c86254ec8a9/0131802730v2.jpeg)
:quality(80)/p7i.vogel.de/wcms/1e/ed/1eed2310aac6373fe3d57c8f9d2809d6/0131673857v2.jpeg)
:quality(80)/p7i.vogel.de/wcms/48/97/4897129d96e4ab9287933406b153ab51/0131163956v2.jpeg)
:quality(80)/p7i.vogel.de/wcms/17/20/1720579fad3f2e89bc1e190e42ee7c8f/0131911326v2.jpeg)
:quality(80)/p7i.vogel.de/wcms/e0/47/e0471aba187b684e713df3c4d63461f8/0131909497v1.jpeg)
:quality(80)/p7i.vogel.de/wcms/db/28/db28c59875bbfbeae78aac866c08ffa3/0131901880v2.jpeg)
:quality(80)/p7i.vogel.de/wcms/bb/51/bb51f90e36d72be4dd360c026642b09c/0131843656v2.jpeg)
:quality(80)/images.vogel.de/vogelonline/bdb/1710600/1710675/original.jpg)
:quality(80)/images.vogel.de/vogelonline/bdb/1682500/1682579/original.jpg)
:quality(80)/images.vogel.de/vogelonline/bdb/1677000/1677080/original.jpg)
:fill(fff,0)/images.vogel.de/vogelonline/companyimg/131900/131910/65.jpg)
:fill(fff,0)/p7i.vogel.de/companies/69/b7/69b7f63f311d9/logo-bimos-tif--2-.jpeg)
:quality(80)/p7i.vogel.de/wcms/51/0a/510ad5a3dcd0860e01bc8a3cc2542de9/0125919434v1.jpeg)
:quality(80)/p7i.vogel.de/wcms/78/ee/78ee7ebac275dfd1c78d568d83214403/0126745641v2.jpeg)
:quality(80)/p7i.vogel.de/wcms/df/88/df8835c56e846aa705d3b9c250a7fa4e/0130918703v1.jpeg)